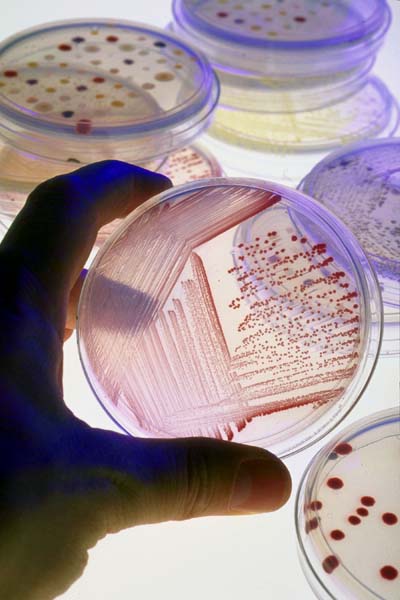
investigatii medicale

investigatii medicale
Detalii produs
Categoria: Aparatura medicala
Medicina de laborator: hematologie, chimie clinica, imunologie, toxicologie/ droguri, markeri virali, markeri hormonali, markeri cardiaci, markeri tumorali, microbiologie, parazitologie, citologie (examen Babes Papanicolau). Histopatologie: Detectie si genotipare HPV; Citologie Babes-Papanicolau in mediu umed; Teste imunohistochimice; Prelucrare histopatologica; Examen histopatologic coloratii speciale.Imagistica: EKG; ecografie abdominala si pelvis.
10 Iunie 2026
Categorii produse
- Accesorii medicale (917)
- Aparate Electrochirurgie (13)
- Aparate Radiochirurgie (6)
- Aparatura de laborator si glucometre (98)
- Aparatura dezinfectie si sterilizare cu UV (13)
- Aparatura medicala (787)
- Aparatura veterinara (89)
- Cardiologie (174)
- Echipamente de diagnostic (10)
- Ecografe (108)
- Electrocautere (44)
- Imagistica (11)
- Instrumentar, lampi chirurgicale (261)
- Magnetoterapie (9)
- Mobilier medical (432)
- Monitoare functii vitale (26)
- Monitorizarea greutatii corporale (1)
- Obstetrica si ginecologie (110)
- Oftalmologie (196)
- ORL (512)
- Pulsoximetre (53)
- Sterilizare (71)
- Stomatologie (27)
- Suplimente nutritive (263)
- Truse medicale (64)
-
Interpretare simptome
semnificatia simptomelor si afectiunile probabile
Afla acum

Urmareste Sfatul Medicului
Aboneaza-te la Newsletter